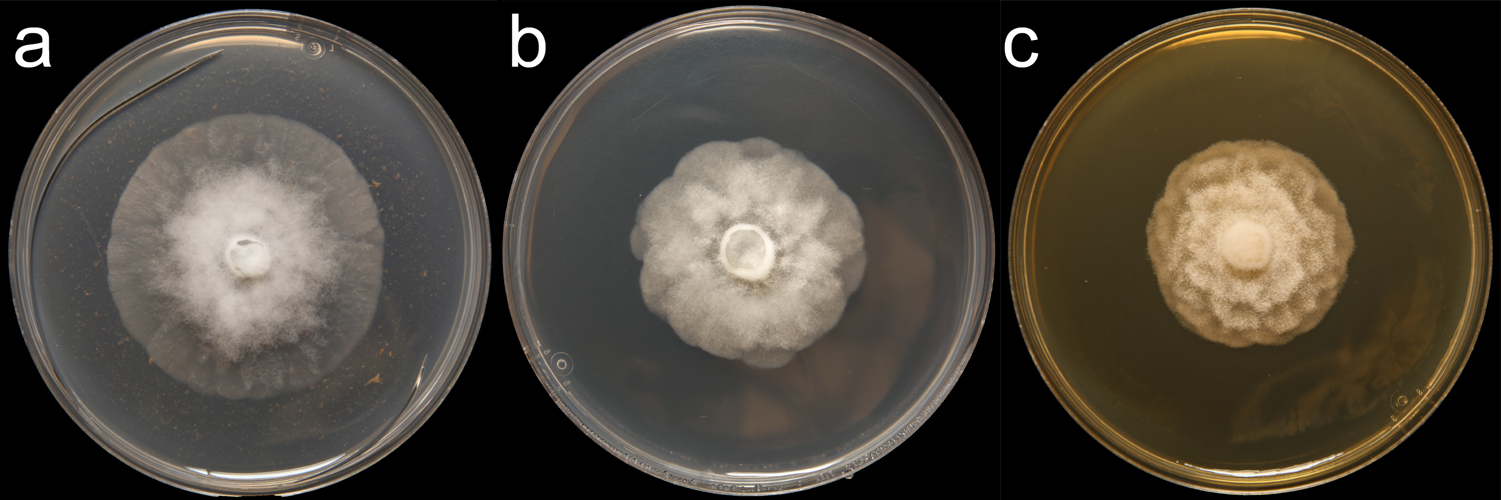

Phytophthora mississippiae
|
Phytophthora spp. in subclade 6b: portion of the seven-loci ML phylogeny featuring the type cultures of 212 described species (by T. Bourret). Notice the position of P. mississippiae Ex-type NRRL 64167 = S&T BL 126. Gloria Abad, USDA S&T.
|
|
Phytophthora spp. in subclade 6b: Morphological Tabular key (PDF) and Tabular key legends (PDF) in IDphy2 KEY SECTION. Notice the data of P. mississippiae Ex-type NRRL 64167 = S&T BL 126. Gloria Abad, USDA S&T.
|
|
Phytophthora mississippiae (CPHST BL 126) colonies of the ex-type grown for 7 days on (a) V8® Agar, (b) potato dextrose agar, and (c) malt extract agar; photo by Krysta Jennings and Leandra Knight, USDA-APHIS-PPQ |
Name and publication
Phytophthora mississippiae X. Yang, W.E. Copes & C.X. Hong (2013)
Yang X, Copes WE, and Hong C. 2013. Phytophthora mississippiae sp. nov., a new species recovered from irrigation reservoirs at a plant nursery in Mississippi. J Plant Pathol Microb 4: 1–7.
Corresponding author: Xiao Yang xiao9@vt.edu
Nomenclature
from Yang et al. (2013)
Mycobank
Etymology
refers to the state of Mississippi where this new species was isolated
Typification
Type: UNITED STATES OF AMERICA from irrigation water of a nursery reservoir, Mississippi, February, 2012, ATCC MYA-4946
Note: No reference to "permanently preserved in a metabolically inactive state" is indicated in the manuscript; see 2013 Nomenclatural Procedures FAQ (ICN/Melbourne Code) Mycologia (G. Abad 1-17-14).
Ex-type: 57J3
Sequences for ex-type in original manuscript: 57J3: ITS rDNA = KF112852, Cox1 = KF112860
Ex-type in other collections
(ET) ATCC MYA-4946, WPC P19994, S&T BL 126 (Abad), 57J3 (Hong)
Molecular identification
Voucher sequences for barcoding genes (ITS rDNA and COI) of the ex-type (see Molecular protocols page)
Phytophthora mississippiae isolate CPHST BL 126 (= P19994 WPC) = ITS rDNA MG865542, COI MH136935
Voucher sequences for Molecular Toolbox with seven genes (ITS, β-tub, COI, EF1α, HSP90, L10, and YPT1
(see Molecular protocols page) (In Progress)
Voucher sequences for Metabarcoding High-throughput Sequencing (HTS) Technologies [Molecular Operational Taxonomic Unit (MOTU)]
(see Molecular protocols page) (In Progress)
Sequences with multiple genes for ex-type in other sources
- NCBI: Phytophthora mississippiae CPHST BL 126
- NCBI: Phytophthora mississippiae 57J3
- EPPO-Q-bank: Phytophthora mississippiae
- BOLDSYSTEMS: Phytophthora mississippiae barcoding COI & ITS)
Position in multigenic phylogeny with 7 genes (ITS, β-tub, COI, EF1α, HSP90, L10, and YPT1)
Clade 6b
Morphological identification
adapted from Hong et al. (2013)
Colonies and cardinal temperatures
Colony colony:
assemblage of hyphae which usually develops form a single source and grows in a coordinated way
morphology after 7 days of growth on potato dextrose agar and malt extract agar with light chrysanthemum pattern, and on V8A with no defined pattern with myceliamycelia:
mass of hyphae constituting the body, or thallus, of fungi and oomycetes; in <em>Phytophthora</em> species, mycelia is coenocytic
concentrated at the center of colonycolony:
assemblage of hyphae which usually develops form a single source and grows in a coordinated way
. Minimum growth temperature 5°C; optimum 25–30°C, and maximum 35°C.
Asexual phase
SporangiaSporangia:
sac within which zoospores form, especially when water is cooled to about 10°C below ambient temperature; in solid substrates, sporangia usually germinate by germ tubes
nonpapillatenonpapillate:
pertaining to the production of a non-distinct, or inconspicuous, papilla at the distal end of the sporangium (cf. papillate and semipapillate)
, sometimes semipapillatesemipapillate:
pertaining to the production of shallow having papilla that are not well developed, shallow and less nipple-like than fully papillate structures
; persistentpersistent:
pertaining to sporangia that remain attached to the sporangiophore and do not separate or detach easily (cf. caducous)
; ovoidovoid:
egg-shaped, with the widest part at the base of the sporangium and the narrow part at the apex
, obpyriformobpyriform:
inversely pear-shaped, i.e. with the widest part at the point of attachment (cf. pyriform)
, ellipsoidellipsoid:
refers to a solid body that forms an ellipse in the longitudinal plane and a circle in cross section; many fungal spores are ellipsoidal or elliptic
(32 x 70 μm); showing nested and extended internal proliferationinternal proliferation:
internal proliferation occurs when the sporangiophore continues to grow through an empty sporangium
and produced in unbranched sporangiophores. Hyphal swellings elongated with irregular shapes, catenulatecatenulate:
having a chain-like form
, or globoseglobose:
having a rounded form resembling that of a sphere
. ChlamydosporesChlamydospores:
an asexual spore with a thickened inner wall that is delimited from the mycelium by a septum; may be terminal or intercalary, and survives for long periods in soil
absent.
Sexual phase
Self-sterile. Sexual stage produced in pairings with Phytophthora cinnamomi, Phytophthora cryptogea, and Phytophthora nicotianae testers. OogoniaOogonia:
the female gametangium in which the oospore forms after fertilization by the antheridium
with ornamented walls with pigmented to golden-brown color at maturation, many oogoniaoogonia:
the female gametangium in which the oospore forms after fertilization by the antheridium
with tapered bases (38 μm diam); antheridiaantheridia:
the male gametangium; a multinucleate, swollen hyphal tip affixed firmly to the wall of the female gametangium (the oogonium)
amphigynousamphigynous:
pertaining to the sexual stage in which the antheridium completely surrounds the stalk of the oogonium (cf. paragynous)
(14 x 20 μm), sometimes bi-cellular; oosporesoospores:
zygote or thick-walled spore that forms within the oogonium after fertilization by the antheridium; may be long-lived
pleroticplerotic:
pertaining to an oospore that fills the oogonium (cf. aplerotic)
(34 μm diam).
Most typical characters
Phytophthora mississippiae is characterized by the presence of oogoniaoogonia:
the female gametangium in which the oospore forms after fertilization by the antheridium
with ornamented walls and catenulated hyphal swellings.
Additional specimen(s) evaluated
Phytophthora mississippiae ex-type CPHST BL 126, duplicate of P19994 (World Phytophthora Collection), which is a duplicate of MYA-4946
Hosts and distribution
Distribution: North America (USA: MS)
Substrate: isolated from irrigation water
Retrieved January 31, 2018 from U.S. National Fungus Collections Nomenclature Database.
Additional references and links
- SMML USDA-ARS: Phytophthora mississippiae
- EPPO Global Database: Phytophthora mississippiae
- Forest Phytophthora of the world: Phytophthora mississippiae
- CABI Digital Library: Phytophthora mississippiae
- Encyclopedia of Life (EOL): Phytophthora mississippiae
- Index Fungorum (IF): Phytophthora mississippiae
- Google All Phytophthora mississippiae
- Google Images Phytophthora mississippiae
- Google Scholar Phytophthora mississippiae
Fact sheet author
Z. Gloria Abad, Ph.D., USDA-APHIS-PPQ-S&T Plant Pathogen Confirmatory Diagnostics Laboratory (PPCDL), United States of America.